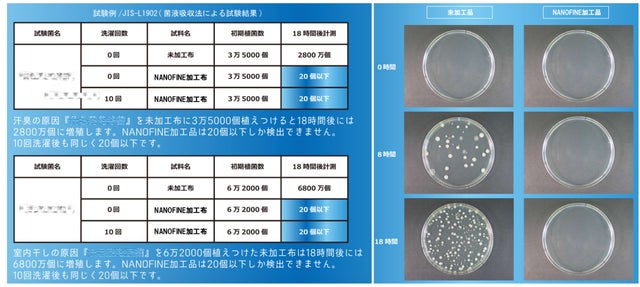

プロジェクト実行者
ストーリー
- 【男の子にも女の子にも】シックでカワイイ、備長炭糸で織り成すモノトーンデザイン。
- 【清潔さを赤ちゃんに】細菌の繁殖を高レベルで抑える制菌加工の生地。
- 【ふかふか/ふわふわ】今治産生地の柔らかなの肌触りと吸水性。快適さを赤ちゃんに。
charcoal開発ストーリー
弊社ハートウエルは1930年創業の愛媛県今治市のタオルメーカーです。タオル製造に90年間携わる中で、様々な高級タオルを生みだし、タオル生地を使ったベビー用品も数多く上市。繊細な糸で織り成す上質なベビーグッズは多くの方にご愛用いただいてきました。

従来の弊社商品の特徴としては、キャラクターやパステル調の色づかいなど、愛らしく、甘いテイストが多いこと。ベビーグッズらしい可愛らしさが人気ですが、この度は趣向を変えた新しい商品開発にトライしました。
目指したのは、シックで落ち着きがあるけれど、でもしっかり愛らしい。そんなムードのベビーシリーズ。また、特殊糸を使った製織実績や自社染色工場を持つ老舗メーカーとしての経験を活用し、ベビーグッズとして最も大切な赤ちゃんの快適さや安全を考慮した機能性を製品にもたせることにこだわりました。
そうして生まれた新しいベビーシリーズの名前は charcoal。

ふんだんに使われた高級な紀州備長炭を練り込んだ糸で表現する自然由来のグレー。主張しない優しいモノトーンが赤ちゃんがもつ生まれながらの可愛らしさを一層引き立てます。備長炭素材の機能性も受け継ぎ、見た目のかわいらしさに実用性がプラスされています。

また備長炭糸に高価で吸水性抜群のコットンの中空糸を交織。後加工では、生地上での菌の繁殖を抑制する制菌加工を施しました。
ヨダレ、食べこぼし、寝汗を生地でしっかり受け止め、細菌の繁殖も防ぎ、生地を常に清潔な状態に保つ。全てを赤ちゃんのためにしつらえた、これまでにないベビーシリーズの誕生です。

紀州備長炭繊維

備長炭は古くから重宝され、機能が衰えないエコでクリーンな素材。今回charcoalに使用している糸は、備長炭の中でも最高峰といわれる紀州備長炭を練り込み、炭の優れた性質を受け継いだ特殊糸です。
紀州備長炭糸の特徴は、高い消臭性と保温性。消臭性は製品を洗うたびによみがえり、機能が半永久的に続きます。食べこぼしの汚れや、寝汗が多い赤ちゃんだからこそ特に有用な機能です。
また、光や熱の吸収効率が良いため、タオルの通気性を備えつつも、赤ちゃんの温かな着用環境を作り出します。
中が空洞の中空糸
備長炭糸と交織しているコットンの中空糸の断面イメージがこちら。

中が空洞のため、普通糸に比べ水分を多く含み保水できる構造になっています。汗でベットリしがちなベビーウェアだからこそ、吸水性に優れる中空糸を用いています。赤ちゃんのヨダレや寝汗をスッと吸い取るよう、一段上の快適性を追求しています。
制菌効果で常に清潔に
製織後の生地に「ナノファイン」の制菌加工を実施。通常の抗菌加工はニオイの原因菌の増殖を防ぐ効果がありますが、ナノファイン制菌加工は、ニオイの原因菌を増殖させないだけでなく、ニオイの原因菌自体を抑制します。
赤ちゃんのヨダレや汗を吸い込んだ生地でも、清潔・衛生的な環境を保つことが可能です。
また、ナノファインの主成分はFDA(米国食品医薬局)でも食品添加物と認可を受けてる「酸化亜鉛」で、抗菌力を持ちながらお肌に限りなくやさしい物質です。サプリメントやベビーパウダー・化粧品などにも使用される安全性が高い日本製の薬剤です。今回使用しているナノファインは耐洗濯性も非常に高く、100回洗濯後も剥離脱落が非常に少なく制菌機能が持続します。
今治産の確かな品質
冒頭の通り、charcoalを手掛ける弊社ハートウエルは愛媛県今治市で90年間タオルを作り続けている、老舗タオルメーカーです。
糸の仕入れ、織り、染色、縫製まで一貫して社内で行っており、90年間で高い製造技術を培ってきました。
今回の製品は織機は30年以上前のものを用いています。ゆっくり時間をかけて丁寧に織り上げた柔らかな風合いをお楽しみください。

デザインとサイズ


リターンについて
ウォッシュタオル/スタイ/おくるみ/スリーパーを組み合わせたリターンを用意しております。スタイとおくるみは単品での購入支援が可能です。

一部リターンについては、大切な方へのギフトのとしてラッピング、熨斗の対応をさせていただきます。熨斗をご希望される方はメッセージにて、表書きとお名前をお送りください。また、必要に応じて配送先宛先等ご入力お願いいたします。


スケジュール
1月20日にプロジェクトを終了し、全て1月中のリターン発送を予定しております。
実行者紹介
株式会社ハートウエル(愛媛県今治市 代表:池永将成)
1930 年創業の今治のタオルメーカー です。OEM 事業に加え、自社オリジナルのタオル製品の生産・販売も手掛けています。今治産地で縫製品の製作にいち早く着手したメーカーで、タオルだけでなく高品質の今治生地でつくるベビー用品もご好評いただいています。2020 年で90 周年を迎え、伝統を礎に、新しい企業文化・商品を創り出そうとしています。

※「夏用Coolマスク」でMakuakeアワードBRONZE賞を受賞致しました。応援購入いただきました皆様、誠にありがとうございました。
リスク&チャレンジ
この度の製品ですが、製造において想定以上の工数を要する可能性がございます。 製造可能な数量とお届けタイミングは慎重に検討しておりますが、リターンの配送に影響が出る場合は事前に活動レポートにて連絡致します。 また、製造において仕様や生地の色が一部変更になるなど、掲載内容に変更が生じる場合にも、お届け前に周知致します。 製造・配送に尽力して参りますので、ご支援のほど宜しくお願い致します。
サポーターからの応援コメント
文章のトップに戻る
応援購入する
このプロジェクトはAll in型です。目標金額の達成に関わらず、プロジェクト終了日の2021年01月20日までに支払いを完了した時点で購入が成立します。
【早割4%】星柄スタイ 1枚

2,417円(税込)
【早割4%Off】
星柄のスタイ 単品です。
組成:コットン96% レーヨン4%
対象年齢0歳〜2歳(28cm×21cm)
2021年1月中に発送予定です。
一般販売予定金額;2,510円(送料込み)
【早割4%】ヘリンボーン柄スタイ 1枚

2,417円(税込)
【早割4%Off】
ヘリンボーン柄のスタイ 単品です。
組成:コットン96% レーヨン4%
対象年齢0歳〜2歳(28cm×21cm)
2021年1月中に発送予定です。
一般販売予定金額;2,510円(送料込み)
【早割4%】ワッフル スタイ 1枚

2,417円(税込)
【早割4%Off】
ワッフルのスタイ 単品です。
組成:コットン96% レーヨン4%
対象年齢0歳〜2歳(20.5cm×24.5cm)
2021年1月中に発送予定です。
一般販売予定金額;2,510円(送料込み)
【早割6%Off】ワッフル スタイ1枚 / 星柄ウォッシュタオル1枚

3,198円(税込)
【早割6%Off】
ワッフルのスタイ1枚と星柄のウォッシュタオル1枚のSETです。
ウォッシュタオルには、ループがついているので
ベビーカーなどに掛けて、便利に使用していただけます。
組成:コットン96% レーヨン4%
スタイ:対象年齢 0歳〜2歳(20.5cm×24.5cm)
ウォッシュタオル:34cm×34cm
2021年1月中に発送予定です。
一般予定販売金額:3,390円(送料込み)
【早割6%Off】星柄スタイ1枚 / ヘリンボーン柄ウォッシュタオル1枚

3,198円(税込)
【早割6%Off】
星柄のスタイ1枚とヘリンボーン柄のウォッシュタオル1枚のSETです。
ウォッシュタオルには、ループがついているので
ベビーカーなどに掛けて、便利に使用していただけます。
組成:コットン96% レーヨン4%
スタイ:対象年齢 0歳〜2歳(28cm×21cm)
ウォッシュタオル:34cm×34cm
2021年1月中に発送予定です。
一般販売予定金額:3,390円(送料込み)
【早割6%Off】ヘリンボーン柄スタイ1枚 / ワッフルウォッシュタオル1枚

3,198円(税込)
【早割6%Off】
ヘリンボーン柄のスタイ1枚とワッフルのウォッシュタオル1枚のSETです。
ウォッシュタオルには、ループがついているので
ベビーカーなどに掛けて、便利に使用していただけます。
組成:コットン96% レーヨン4%
スタイ:対象年齢 0歳〜2歳(28cm×21cm)
ウォッシュタオル:34cm×34cm
2021年1月中に発送予定です。
一般予定販売金額:3,390円(送料込み)
【早割7%】星柄フード付きバスタオル

6,923円(税込)
【早割7%Off】
星柄フード付きバスタオルです。
湯上り時にさっと頭から掛けられるため
湯冷め防止に使用いただけます。
組成:コットン96% レーヨン4%
サイズ:60cm×120cm
2021年1月中に発送予定です。
一般販売予定金額;7,370円(送料込み)
【早割7%】ヘリンボーン柄フード付きバスタオル

6,923円(税込)
【早割7%Off】
ヘリンボーン柄フード付きバスタオルです。
湯上り時にさっと頭から掛けられるため
湯冷め防止に使用いただけます。
組成:コットン96% レーヨン4%
サイズ:60cm×120cm
2021年1月中に発送予定です。
一般販売予定金額;7,370円(送料込み)
ギフト【早割7%】ワッフル フード付きバスタオル

7,173円(税込)
こちらはギフト対応可能なリターンです。
大切な方へのギフトのとしてラッピング、熨斗の対応をさせていただきます。
熨斗をご希望される方は、
プロジェクトページの「実行者へ問合せ」より、メッセージにて表書きとお名前をお送りください。また、必要に応じて配送先宛先等ご入力お願いいたします。
【早割7%Off】
ワッフルのフード付きバスタオルです。
湯上り時にさっと頭から掛けられるため
湯冷め防止に使用いただけます。
組成:コットン96% レーヨン4%
サイズ:60cm×120cm
2021年1月中に発送予定です。
一般販売予定金額;7,620円(送料・ラッピング代込み)
【早割8%Off】星柄 おくるみ1枚 /ヘリンボーン柄ウォッシュタオル 1枚

8,074円(税込)
【早割8%Off】
星柄のおくるみ1枚とヘリンボーン柄ウォッシュタオル1枚のSETです。
おくるみは、ベビーカーにかけるブランケットとしても
おむつ交換の際に敷いても使いやすいサイズです。
ウォッシュタオルは、ループがついているため
ベビーカー などにかけて便利でご使用いただけます。
組成:コットン96% レーヨン4%
おくるみ:80cm×80cm
ウォッシュタオル:34cm × 34cm
2021年1月中に発送予定です。
一般販売予定金額:8,690円
【早割8%Off】ワッフル おくるみ1枚 /星柄ウォッシュタオル 1枚

8,074円(税込)
【早割8%Off】
ワッフルのおくるみ1枚と星柄ウォッシュタオル1枚のSETです。
おくるみは、ベビーカーにかけるブランケットとしても
おむつ交換の際に敷いても使いやすいサイズです。
ウォッシュタオルは、ループがついているため
ベビーカー などにかけて便利でご使用いただけます。
組成:コットン96% レーヨン4%
おくるみ:80cm×80cm
ウォッシュタオル:34cm × 34cm
2021年1月中に発送予定です。
一般販売予定金額;8,690円(送料込み)
ギフト【早割8%Off】ヘリンボーン柄おくるみ1枚 /ワッフル タオル 1枚

8,324円(税込)
こちらはギフト対応可能なリターンです。
大切な方へのギフトのとしてラッピング、熨斗の対応をさせていただきます。
熨斗をご希望される方は、
プロジェクトページの「実行者へ問合せ」より、メッセージにて表書きとお名前をお送りください。また、必要に応じて配送先宛先等ご入力お願いいたします。
【早割8%Off】
ヘリンボーン柄のおくるみ1枚とワッフルウォッシュタオル1枚のSETです。
おくるみは、ベビーカーにかけるブランケットとしても
おむつ交換の際に敷いても使いやすいサイズです。
ウォッシュタオルは、ループがついているため
ベビーカー などにかけて便利でご使用いただけます。
組成:コットン96% レーヨン4%
おくるみ:80cm×80cm
ウォッシュタオル:34cm × 34cm
2021年1月中に発送予定です。
一般販売予定金額;8,940円(送料・ラッピング込み)
【早割10%Off】ヘリンボーン柄スタイ1枚 /ワッフル スリーパー1枚

9,207円(税込)
【早割10%Off】
ヘリンボーン柄のスタイ1枚とワッフルのスリーパー1枚のSETです。
着崩れしにくく着脱しやすいスリーパーは、
睡眠時だけでなく食事など、普段お過ごしの際にも便利に使用していただけます。
組成:コットン96% レーヨン4%
スタイ:対象年齢 0歳〜2歳(28cm×21cm)
スリーパー:着丈56cm × 身丈40cm
2021年1月中に発送予定です。
一般販売予定金額:10,120円(送料込み)
【早割10%Off】ワッフル スタイ1枚 /星柄スリーパー1枚

9,207円(税込)
【早割10%Off】
ワッフルのスタイ1枚と星柄のスリーパー1枚のSETです。
着崩れしにくく着脱しやすいスリーパーは、
睡眠時だけでなく食事など、普段お過ごしの際にも便利に使用していただけます。
組成:コットン96% レーヨン4%
スタイ:対象年齢 0歳〜2歳(20.5cm×24.5cm)
スリーパー:着丈56cm × 身丈40cm
2021年1月中に発送予定です。
一般販売予定金額:10,120円(送料込み)
ギフト【早割10%Off】星柄スタイ1枚 /ヘリンボーン柄スリーパー1枚

9,457円(税込)
こちらはギフト対応可能なリターンです。
大切な方へのギフトのとしてラッピング、熨斗の対応をさせていただきます。
熨斗をご希望される方は、
プロジェクトページの「実行者へ問合せ」より、メッセージにて表書きとお名前をお送りください。また、必要に応じて配送先宛先等ご入力お願いいたします。
【早割10%Off】
星柄のスタイ1枚とヘリンボーン柄のスリーパー1枚のSETです。
着崩れしにくく着脱しやすいスリーパーは、
睡眠時だけでなく食事など、普段お過ごしの際にも便利に使用していただけます。
組成:コットン96% レーヨン4%
スタイ:対象年齢 0歳〜2歳(28cm×21cm)
スリーパー:着丈56cm × 身丈40cm
2021年1月中に発送予定です。
一般販売予定金額 10,370円(送料・ラッピング代込み)
「Makuake(マクアケ)」は、実行者の想いを応援購入によって実現するアタラシイものやサービスのプラットフォームです。このページは、 プロダクトカテゴリの 「備長炭糸を贅沢に使った清潔で衛生的な今治産ベビーシリーズが登場!」プロジェクト詳細ページです。






